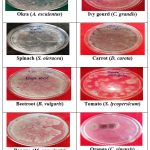

Introduction
The isolation and identification of fungi from fruits and vegetables constitute a critical aspect of food safety and quality control. Traditional methods for identifying fungi involve morphological and physiological assessments, which remain prevalent despite advancements in molecular techniques.1 Fungi, including yeasts and molds, are ubiquitous in various environments and can contaminate food products, potentially producing mycotoxins even in the absence of visible growth.2,3
In medical mycology, the processes of isolating and identifying fungi play a crucial role in managing fungal infections effectively.4 With more than 200 fungal species known to infect humans, precise identification is vital for determining the appropriate treatment. These procedures are essential for diagnosing and treating fungal infections, despite facing obstacles such as expenses and contamination risks. They are particularly important in addressing the increasing concern of antifungal-resistant pathogens Furthermore, the rise of resistant fungi has become a major threat to public health, necessitating additional research to comprehend and combat these pathogens Martins-Santana et al., 2023).5,6 This study aids in early detection and control of fungal contamination and there by supporting safer food handling practices in local markets.
Materials and Methods
Sample collection
A total of ten different fruits and vegetables showing signs of fungal infection were collected from Rythubazar, C-Camp, Kurnool. The collected samples comprised banana (Musa acuminata), papaya (Carica papaya), orange (Citrus sinensis), carrot (Daucus carota), ivy gourd (Coccinia grandis), okra (Abelmoschus esculentus), beetroot (Beta vulgaris), spinach (Spinacia oleracea), brinjal (Solanum melongena), and tomato (Lycopersicon esculentum). All samples were aseptically transferred to the laboratory in sterile polythene bags for further examination.
Sample Preparation
Fruits and vegetables were cut from the lesion edges using a disinfected knife. The samples were surface-sterilized using 0.1 g/L sodium hypochlorite solution (2% chlorine) for 5 minutes, rinsed thrice with distilled water, and homogenized in a blender. The homogenate was serially diluted with 8.5% NaCl normal saline solution.7
Culture media preparation
Potato Dextrose Agar (PDA) is a widely used medium for culturing fungi, including molds and yeasts. To prepare PDA, 200 g of peeled, chopped potatoes are boiled in 500 mL of distilled water for 30 minutes, then filtered and diluted to 1000 mL. Next, 20 g of dextrose and 15 g of agar are added and dissolved by heating. The pH is adjusted to 5.6 ± 0.2, and 0.3 g/L of chloramphenicol may be added to prevent bacterial growth. The medium is sterilized at 121°C for 15 minutes, cooled to 45–50°C, poured into sterile Petri dishes, and stored at 4°C until use. PDA provides essential nutrients for fungal growth and is widely applied in microbiology and plant pathology.8,9
Isolation of fungi
The isolation of fungi involves collecting samples from spoiled fruits and vegetables preparing them for culture. Solid samples are mixed with sterile water or saline and diluted to reduce microbial load. A small amount of the sample is then spread on Potato Dextrose Agar (PDA) or Sabouraud Dextrose Agar (SDA) plates containing antibiotics to prevent bacterial growth. Plates are incubated at 25–30°C for 5–7 days, allowing fungal colonies to develop. Distinct colonies are picked and transferred to fresh media for purification. Fungal identification is done using Lactophenol Cotton Blue (LPCB) staining and microscopic examination based on spore and hyphal structures. Pure cultures can be stored at 4°C on PDA slants for short-term use or preserved long-term in glycerol at –80°C. This method is widely used in microbiology and plant pathology for fungal identification and study.8,10
Identification of the isolated fungi
Fungal isolates were identified after incubation at 30°C for 6–7 days. Small 1 cm² blocks of Potato Dextrose Agar (PDA) were transferred to sterile slides, stained with 0.5% lactophenol blue, and examined under a light microscope at 10 × magnifications. Key features such as colony growth, hyphal structure, reproductive structures (sporangia/conidia), pigmentation, and spore type were recorded for identification following standard methods.8,11
Pathogencity Test
The pathogenicity test was conducted to determine whether the isolated fungi caused fruit spoilage.12,13 Healthy fruits were surface sterilized with 90% ethanol, and 4 mm incisions were made using a sterile cork borer. Fungal cultures from Potato Dextrose Agar (PDA) were cut with a similar cork borer and placed into the incisions under sterile conditions. The inoculated wounds were sealed with petroleum jelly to prevent contamination. Control fruits with incisions but no fungal inoculation were kept in sterile polythene bags with moistened cotton wool to maintain humidity. All samples were incubated at 28°C for 5 days, and symptoms were observed after 72 hours. Fungi were then re-isolated from infected fruits and compared with the original isolates to confirm their role in spoilage.
Statistical significance
All the data are expressed as mean ± SEM. Comparison of the obtained values for the above parameters and the extracts with control group, was done through making use of ANOVA followed by Dunnett’s test. The values of p < 0.05 and p < 0.01 were considered to indicate a significant difference between the groups
Results
Isolation and Identification of fungal isolates
|
Plate 1: Isolated fungal colonies of different vegetables and fruits |
 |
Plate 2: Microscopic observation of Fungal isolates. |
Table 1: Identification of fungal isolates from spoiled fruits and vegetables
| Vegetables & Fruits | Spoilage Characteristics | Colony Appearance | Microscopic Features | Identified Organism |
| Okra (A. esculentus) | White cottony fibres, moist | White-grey cottony colonies, irregular spread | Non-septate hyphae, rhizoids, sporangiophores | R. stolonifer |
| Whitish moist flat fibres | Shiny, woolly to cottony colonies | Hyaline septate hyphae, conidiophores, phialides | Fusarium sp. | |
| Spinach (S. oleracea) | White cottony fibres, water-soaked | White-black cottony spread | Septate hyphae, conidia, vesicles | Aspergillus sp. |
| Water-soaked depression | Shiny, smooth cream-white colonies | Septate hyphae, short inflated conidiophores, black-walled conidia | Candida sp. | |
| Beetroot (B.vulgaris) | Greenish sunken depression | White-black smooth scattered colonies | Unbranched conidiophores, swollen vesicles, septate hyphae | Aspergillus sp. |
| Ivy gourd (C. grandis) | Wrinkled, spongy white deposits | Black colonies, dense cottony mycelia | Broad non-septate hyphae, rhizoids, sporangia | Rhizopus sp. |
| Carrot (D. carota) | Black moist water-soaked, spores visible | White-black dense mycelial growth | Septate hyphae, conidiophores, vesicles | Aspergillus spp. |
| Tomato (S. lycopersicum) | Wrinkled, depressed | Whitish turning brown-black | Non-septate mycelia, branching sporangiosphores | Rhizopus stolonifer |
| Wrinkled, depressed | White-grey cottony fibers | Prostrate hyphae, sporangiophore, sporangium | Mucor spp. | |
| Brinjal (S. melongena) | Large sunken depression | White-black cottony colonies | Septate hyphae, conidia, vesicles | Aspergillus spp. |
| Pawpaw (C. papaya) | Large sunken depression | White colony with black conidia | Long conidiophore, vesicle, conidia | Aspergillus spp. |
| Wrinkled, water-soaked depression | Whitish colony turning brown-black | Non-septate mycelia, ovoid sporangiosphore | Rhizopus spp. | |
| Orange (C. sinensis) | Dark brown discoloration, gas formation | White with black edges | Septate hyphae, long conidiophore, conidia | Aspergillus spp. |
| Spongy with gas production | White-grey filamentous colonies | Branched conidiophores, brush-like conidia clusters | Penicillium spp. | |
| Banana (M. acuminata) | Dry, wrinkled, rough, blackish, moist | White-grey fluffy mycelium | Mycelium with sporangia and spores | Mucor spp. |
A total of six fungal genera, namely Aspergillus, Fusarium, Mucor, Rhizopus, Penicillium, and Candida, were isolated from four fruit and six vegetable samples. Mucor sp. was identified in banana (M. acuminata), while Aspergillus sp. and Rhizopus sp. were recovered from pawpaw (C. papaya). Similarly, Aspergillus sp. and Mucor sp. were found in orange (C. sinensis), and Aspergillus sp. was detected in carrot (D. carota). Rhizopus sp. was isolated from ivy gourd (C. grandis), whereas Rhizopus sp. and Fusarium sp. were found in okra (A. esculentus). Beetroot (B. vulgaris) harbored Aspergillus sp., and both Aspergillus sp. and Candida sp. were detected in spinach (S. oleracea). Aspergillus sp. was also isolated from brinjal (S. melongena), while tomato (S. lycopersicum) yielded Rhizopus sp. and Mucor sp. (Plate1, 2 & Table 1).
Table 2: Frequency of occurrence of each isolates in Vegetable & fruit samples
| Fruit/Vegetable | Fungal Species | Frequency (%) Mean ± SEM |
| Okra (A. esculentus) | Rhizopus sp., Fusarium sp. | 74.2 ± 0.70*, 26.8 ± 0.66 |
| Spinach (S. oleracea) | Aspergillus sp., Candida sp. | 64.3 ± 0.46**, 26.7 ± 0.70* |
| ivy gourd (C. grandis) | Rhizopus sp. | 59.3± 0.66* |
| Beetroot (B. vulgaris) | Aspergillus sp. | 72.5 ±1.77 |
| Carrot (D. carota) | Aspergillus sp. | 66.3± 0.24* |
| Tomato (L. esculentum) | Rhizopus sp., Mucor sp. | 48.7 ± 0.40, 52.3 ± 0.70* |
| Brinjal (S. melongena) | Aspergillus sp. | 57.4 ±0.46** |
| Pawpaw (C. papaya) | Aspergillus, Rhizopus sp. | 33.7± 0.28* 66.3%± 0.44 |
| Orange (C. sinensis) | Aspergillus sp., Mucor sp. | 68.4± 0.68**, 42.6± 0.66 |
| Banana (M. acuminata) | Mucor sp. | 74.6± 0.99 |
All the data are expressed as mean ± SEM, n=6, * p < 0.05 and **p < 0.01 when compared with control group One way ANOVA followed by Dunnett’s tes
Among the isolated fungi, Aspergillus was the most common, causing major spoilage in fruits and vegetables. It was most frequently found in spinach (S. oleracea), beetroot (Beta vulgaris), carrot (D. carota), brinjal (S. melongena), papaya (C. papaya), and orange (C. sinensis). In okra (A. esculentus), Rhizopus sp. was more common than Fusarium sp., while Aspergillus sp. was found more often than Candida sp. in spinach. Mucor sp. dominated in tomato (S. lycopersicum), Rhizopus sp. was more frequent than Aspergillus sp. in papaya, and Aspergillus sp. was more common than Mucor sp. in orange. Candida sp. was the least frequent, found only in spinach (Table 2).
Table 3: Pathogenicity test
| Fungal Species | Inoculated Fruit/Vegetable | Observed Spoilage |
| Aspergillus sp. | Spinach, beetroot and carrot | Cottony growth, discoloration |
| Rhizopus sp. | Okra, pawpaw | Sunken lesions, spongy texture |
| Mucor sp. | Tomato, banana | Moist, rough surface |
| Fusarium sp. | Okra | White, moist growth |
| Candida sp. | Spinach | Watery lesions |
| Penicillium sp. | Orange | Gas production, spongy texture |
Pathogenicity tests confirmed that these fungi caused spoilage, as they reproduced decay symptoms when reintroduced into healthy fruits.
Discussion
In this study, Aspergillus sp. and Rhizopus sp. isolated from pawpaw (C. papaya) were responsible for soft rot in pawpaw and tomato are common pathogens which is consistent with findings by Baiyewu et al. (2007).12 The isolation of R. stolonifer and Mucor sp. from tomato (S. lycopersicum) supports previous reports by Efiuvwevwere (2000),18 Chuku et al. (2008),19 and Purseglove (1977),20 who identified Fusarium sp. and R. stolonifer as major causes of tomato soft rot. The colonization of fruits and vegetables by spoilage microorganisms is a critical stage in microbial deterioration. Fungal spoilage is influenced by multiple factors occurring at different handling stages, from pre-harvest to consumption. These factors include the physiological and physical condition of the produce and environmental conditions such as temperature and humidity. Efiuvwevwere (2000)18 also reported that high moisture and relative humidity promote fungal growth in farm produce, reducing their storage life. The predominance of Aspergillus spp. across multiple samples suggests its widespread occurrence in fruits and vegetables, potentially posing risks related to spoilage and mycotoxin contamination.14 & 15 The identification of Fusarium sp. further highlights the importance of monitoring fungal contamination due to its potential impact on food safety and agricultural productivity.16
Conclusions
Fungal contamination is a major cause of fruit and vegetable spoilage. Proper post-harvest handling and timely fungicide application can mitigate fungal infections and reduce mycotoxin risks. Further studies should explore insect-mediated fungal transmission. To minimize spoilage, fruits and vegetables should be consumed fresh or cooked. Creating storage conditions unfavorable for fungal growth can enhance food safety.
Acknowledgement
This work was supported by Rayalaseema University administration, Kurnool, AP., India.
Funding Sources
The author(s) received no financial support for the research, authorship, and/or publication of this article. Conflict of Interest The authors do not have any conflict of interest.
Conflict of Interest
The authors do not have any conflict of interest.
Data Availability Statement
This study did not involve human participants, and therefore, informed consent was not required.
Ethics Statement
This research did not involve human participants, animal subjects, or any material that requires ethical approval.
Informed Consent Statement
This study did not involve human participants, and therefore, informed consent was not required.
Permission to reproduce material from other sources
Not Applicable
Author Contributions
Bommana Kavitha: Colletion of Data, Methodology, Writing – Original Draft.
Guneti Sri Ranganayakulu: Writing – Review & Editing and met thoroughly the manuscript, offered valuable insights and suggestions to improve it.
Refereces
- Sangeetha J, Thangadurai D. Global Food Safety: Microbial Interventions and Molecular Advancements. Apple Academic Press; 2012.
- Erkmen O. Food Microbiology: Principles into Practice. Wiley-Blackwell; 2022.
CrossRef - Gourama H, Fung DYC. Mycotoxins: Risks in Plant, Animal, and Human Systems. CAST (Council for Agricultural Science and Technology); 2023.
- Law JW-F. A comprehensive review on the techniques for biofilm removal. Front Microbiol. 2019;10:1340.
- Koffi Y, Kouadio A, N’Guessan K, Traoré K, Konan Y, and Kone B. Emerging antifungal resistance: A global concern. Journal of Fungi. 2023; 9(2):123.
- Martins-Santana L, Ribeiro D, Silva D, Oliveira C, and Santos R. Advances in antifungal therapies: Combating resistance. Current Fungal Infection Reports. 2023; 17(1):45–58.
- Aneja, K.R., 2003. Experiments in Microbiology, Plant Pathology and Biotechnology. 4th ed. New Delhi: New Age International Publishers.
- Barnett HL, Hunter BB. Illustrated Genera of Imperfect Fungi. 4th ed. New York: Macmillan Publishing; 1987.
- Harrigan WF. Laboratory Methods in Food Microbiology. 3rd ed. Academic Press; 1998.
- Watanabe T. Pictorial Atlas of Soil and Seed Fungi. CRC Press; 2002.
CrossRef - Domsch KH, Gams W, Anderson TH. Compendium of Soil Fungi. Vol. 1 & 2. Eching, Germany: IHW-Verlag; 1993.
- Baiyewu RA, Amusa NA, Ayoola OA, Babalola OO. Survey of the postharvest diseases and aflatoxin contamination of marketed Pawpaw fruit (Carica papaya) in Southwestern Nigeria. Afr J Agric Res. 2007 Apr 30;2(4):178-81.
- Chukwuka KS, Okonko IO, Adekunle AA. Microbial ecology of organisms causing pawpaw (Carica papaya) fruit decay in Oyo State, Nigeria. Am Eurasian J Toxicol Sci. 2010;2(1):43-50.
- Pitt JI, Hocking AD. Fungi and food spoilage. 3rd ed. Springer; 2009.
CrossRef - Samson RA, Houbraken J, Thrane U, Frisvad JC, Andersen B. Food and indoor fungi. CBS-KNAW Fungal Biodiversity Centre; 2014.
- Summerell BA. Fusarium species: An emerging threat to global wheat production. Curr Opin Microbiol. 2019;50:136-41.
- Klich MA. Aspergillus flavus: The major producer of aflatoxin. Mol Plant Pathol. 2007;8(6):713-22.
CrossRef - Efiuvwevwere BJO. Microbial spoilage agents of tropical and subtropical fruits and vegetables. In: Wilson SA, editor. Postharvest Pathology of Fruits and Vegetables. Academic Press; 2000. p. 12-35.
- Chuku EC, Ogbonna DN, Onuegbu BA, Adeleke MT. Comparative studies on the fungi and biochemical characteristics of snake gourd (Trichosanthes cucumerina Linn) and tomato (Lycopersicon esculentum Mill) in Rivers State, Nigeria. Afr J Biotechnol. 2008;7(4):425-33.
- Purseglove JW. Tropical crops: Dicotyledons. Longman; 1977.

